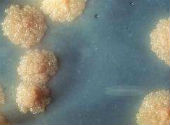
Tuberculoză

Aproximativ 1000 de persoane contactează tuberculoză zilnic la nivelul Europei şi al Asiei Centrale, în ciuda unui declin mondial al acestei boli, se arată într-un raport din luna martie al Centrului European pentru Prevenirea şi Controlul Bolilor. Raportul, în parteneriat cu Organizaţia Mondială a Sănătăţii (OMS), scoate în evidenţă faptul că Europa nu va scăpa de această boală înaintea următorului secol dacă se menţine rata actuală de eradicare a bolii, în special din cauza prevalenţei în ţările din estul regiunii.
Aproximativ 1000 de persoane contactează tuberculoză zilnic la nivelul Europei şi al Asiei Centrale, în ciuda unui declin mondial al acestei boli, se arată într-un raport din luna martie al Centrului European pentru Prevenirea şi Controlul Bolilor. Raportul, în parteneriat cu Organizaţia Mondială a Sănătăţii (OMS), scoate în evidenţă faptul că Europa nu va scăpa de această boală înaintea următorului secol dacă se menţine rata actuală de eradicare a bolii, în special din cauza prevalenţei în ţările din estul regiunii.
În imagine: Colonii bacteriene de M. tuberculosis. Sursa: Centrul pentru Prevenirea si Controlul Bolilor
„Tuberculoza multirezistentă, (Multi-resistance tuberculosis MDR-TB) încă face ravagii în regiunea europeană, făcând din aceasta cea mai afectată zonă la nivel mondial”, afirmă într-o declaraţie Zsuzsanna Jakab, directorul regional pe Europa al OMS.
Aceasta subliniază că 50% dintre cazuri sunt raportate şi doar jumătate dintre acestea sunt tratate cu succes.
În 2013 au fost raportate aproximativ 360.000 cazuri de tuberculoză, 85% dintre acestea înregistrându-se în 18 ţări „prioritare” din Europa de Est şi Asia Centrală, incluzând România, Georgia, Turcia, Uzbekistan, Kazakhstan şi Rusia.
Majoritatea celor 38.000 de cazuri de deces produse de tuberculoză au fost, de asemenea, înregistrate în Europa Centrală şi foste republici sovietice.
„Tuberculoza este strâns corelată cu condiţiile socio-economice dintr-un stat, precum nutriţia, nivelul de trai, sistemul de sănătate”, scrie Marieke van der Werf, purtătorul de cuvânt al Centrului European pentru Prevenirea si Controlul Bolilor, într-un email adresat AFP.
„S-a observat că în Europa numărul de cazuri de tuberculoză este mai mare în statele în care veniturile sunt mai mici şi în cele în care inegalităţile cu privire la venituri sunt mari.”
Rata scăzută de detecţie şi de recuperare în urma bolii din multe state presupune că autorităţile sanitare trebuie „să mărească considerabil accesul la tratamente sigure, raţionale şi eficiente împotriva tuberculozei, cât şi diagnosticarea şi tratarea rapidă”, adaugă Zsuzsanna Jakab de la OMS.
Tuberculoza este a doua boală infecţioasă ca număr de decese la nivel mondial după SIDA, cu 1,5 milioane de decese înregistrate în 2013, în comparaţie cu 1,6 milioane de decese provocate de SIDA în 2012.
Ziua mondială a tuberculozei este marcată anual pe 24 martie în încercarea de a sensibiliza cu privire la prevenţie şi tratament.
Traducere de Vîjială Sergiu după tuberculosis-declining-europe, cu acordul editorului

